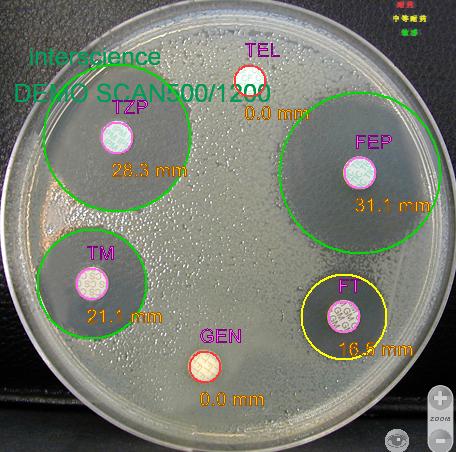

| 提交詢價(jià)信息 |
| 發(fā)布緊急求購(gòu) |
價(jià)格:電議
所在地:上海
型號(hào):SCAN1200
更新時(shí)間:2018-09-07
瀏覽次數(shù):2886
公司地址:上海市曹安路1877號(hào)805室
![]()
wisdomsci(先生)
上海智理科學(xué)儀器有限公司專業(yè)代理歐、美、日先進(jìn)進(jìn)口科學(xué)儀器,國(guó)產(chǎn)優(yōu)秀儀器,實(shí)驗(yàn)室家具及相關(guān)消耗品,專業(yè)涉及化工輕工、電子、醫(yī)學(xué)制藥、食品、紡織、涂料、日用化學(xué)、化妝品及生命科學(xué),在國(guó)內(nèi) 全國(guó)特別是華東地區(qū)具有廣泛的客戶基礎(chǔ)和良好的商業(yè)信譽(yù)。
上海智理科學(xué)儀器有限公司經(jīng)過(guò)多年的發(fā)展,已經(jīng)在同行業(yè)中確立了多方面的領(lǐng)先地位,無(wú)論在公司規(guī)模、人員素質(zhì)、經(jīng)營(yíng)品種、銷售能力和售后服務(wù)等各方面獲得了同行及用戶的廣泛認(rèn)可。
上海智理科學(xué)儀器有限公司代理的產(chǎn)品多為世界頂級(jí)品牌。主要產(chǎn)品為通用實(shí)驗(yàn)設(shè)備、 化工輕工儀器 、電子、農(nóng)業(yè)食品相關(guān)儀器、生命科學(xué)儀器、理化分析儀器、微生物儀器、消耗品及試劑。
現(xiàn)已成為:
法國(guó)Interscience:無(wú)菌均質(zhì)袋,拍擊式均質(zhì)器,重量稀釋器,螺旋接種儀,液體分裝泵,全自動(dòng)菌落計(jì)數(shù)器中國(guó)總代理;
韓國(guó)G-won智元:谷物水份測(cè)定儀,種子水份測(cè)定儀,糖度計(jì),鹽度計(jì),酸度計(jì)等中國(guó)總代理;
美國(guó)QUANTEK:殘氧儀,頂空分析儀,氧氣分析儀,二氧化碳分析儀等中國(guó)總代理
美國(guó)Thermo fisher:Labsystems酶標(biāo)儀和洗板機(jī)及移液器等代理
Euteh優(yōu)特水質(zhì)儀器代理
Orion奧立龍水質(zhì)儀器代理
瑞士ROTRONIC 水分活度測(cè)定儀中國(guó)代理
美國(guó)X-rite色差儀等代理
日本Konica minolta色差儀代理
美國(guó)Ohaus奧豪斯天平,水分儀,工業(yè)稱中國(guó)代理
美國(guó)Brookfield粘度計(jì),流變儀,質(zhì)構(gòu)儀,恒溫水槽等
(產(chǎn)品品牌不斷增加中,同時(shí)歡迎各知名儀器與我們合作代理銷售。同時(shí)歡迎各地代理銷售我公司產(chǎn)品)
Wisdom Shanghai Instrument Co., Ltd. is a professional agent of Europeans, American and Japanese famous scientific instruments, domestic excellent instruments and related consumables. Professionals involved in food, medical pharmaceutical, life science, chemical, light industry, electronics, textiles and cosmetics. In the country has a broad customer base and good business reputation.
Brands include:
INTERSCIENCE, G-WON, THERMO FISHER, ROTRONIC, X-RITE, KONICA MINOLTA, OHAUS, BROOKFILED AND ETC.
Tel:; Fax:
地址:上海市曹安路1877號(hào)(曹安國(guó)際商城)805室(郵編:201824)
e-mail:wisdomsci#(#改成@)
付款信息:
公司名稱:上海智理科學(xué)儀器有限公司
開(kāi) 戶 行:浦發(fā)銀行閔行支行
賬 號(hào):076499-4122924383
操作演示:
Scan1200 全自動(dòng)菌落計(jì)數(shù)器
特 點(diǎn):
培養(yǎng)皿直徑:標(biāo)準(zhǔn)的90mm和55mm
彩色CCD分辨率:1280*960像素pixels
檢測(cè)方式:全自動(dòng)或手動(dòng)
光源:長(zhǎng)壽命的LED光源
光源組合:6種組合形式的光源和背景顏色
語(yǔ)言:中文/英語(yǔ)/法語(yǔ)/日文/俄語(yǔ)等
背景:黑/白
材質(zhì):不銹鋼
稀釋倍數(shù):用戶自定義模式
數(shù)據(jù)接口:IEEE 1394
菌落分辨率:<0.05mm
外形尺寸:27*27*38CM;
抑菌圈分辨率::<0.05mm
電源:220V/110V,50/60Hz
計(jì)數(shù)時(shí)間:<0.5s
重量:8.7kg
SCAN軟件界面:

|
|
|
![]() |
|
條碼器閱讀器
|
Compact Dry
adaptor |
PetriFilm®
adaptor |
RIDA® count /
Sanita-kun® adaptor |
免責(zé)聲明:以上所展示的[SCAN1200 自動(dòng)影像分析菌落計(jì)數(shù)儀]信息由會(huì)員[上海智理科學(xué)儀器有限公司]自行提供,內(nèi)容的真實(shí)性、準(zhǔn)確性和合法性由發(fā)布會(huì)員負(fù)責(zé)。